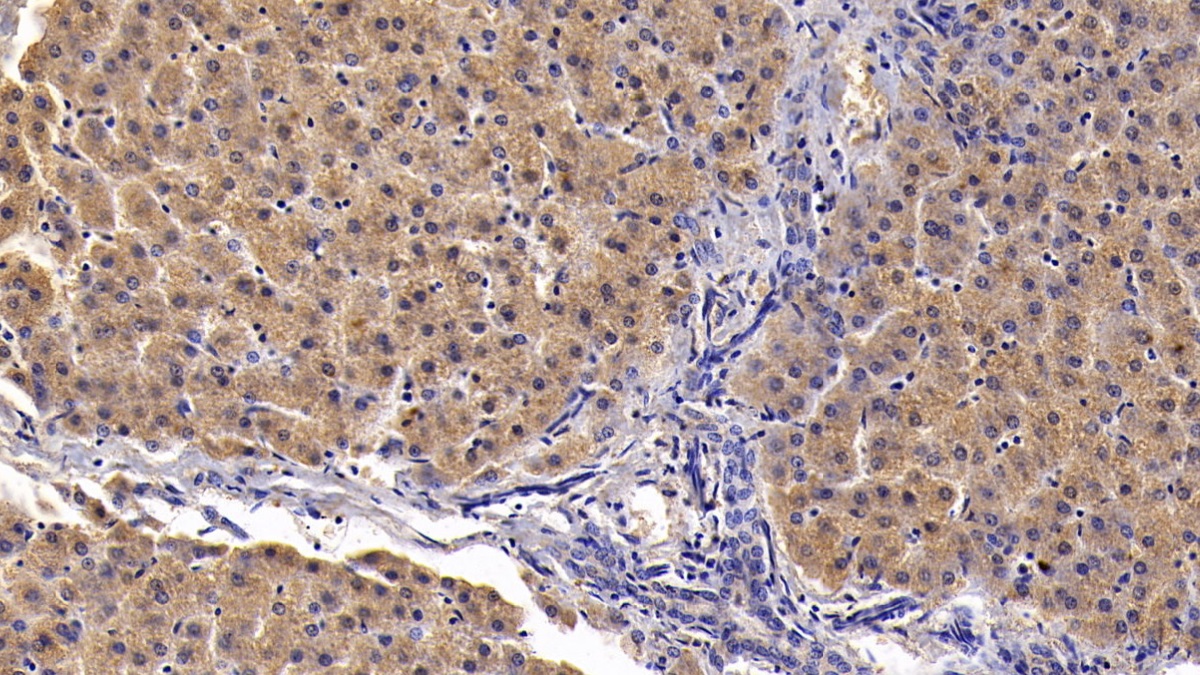

Monoclonal Antibody to Clusterin (CLU) 

CLU; TRPM2; KUB1; CLI; APOJ; SGP2; AAG4; APO-J; SP-40; Apolipoprotein J; Complement Lysis Inhibitor; 40,Sulfated Glycoprotein 2; Testosterone-Repressed Prostate Message 2
- UOM
- FOB US$ 129.00 US$ 301.00 US$ 430.00 US$ 1,075.00 US$ 4,300.00
- Quantity
Overview
Properties
- Product No.MAB180Po27
- Organism SpeciesSus scrofa; Porcine (Pig) Same name, Different species.
- ApplicationsWB; IHC
If the antibody is used in flow cytometry, please check FCM antibodies.
Research use only - DownloadInstruction Manual
- CategoryApoptosisTumor immunityInfection immunity
- SourceMonoclonal antibody preparation, Host Mouse
- Ig Isotype IgG1 Kappa, Clone Number D21
- PurificationProtein A + Protein G affinity chromatography
- LabelNone
- Immunogen RPB180Po01-Recombinant Clusterin (CLU)
- Buffer Formulation0.01M PBS, pH7.4, containing 0.05% Proclin-300, 50% glycerol.
- TraitsLiquid, Concentration 1mg/ml
Sign into your account
Share a new citation as an author
Upload your experimental result
Review

Contact us
Please fill in the blank.
Specifity
The antibody is a mouse monoclonal antibody raised against CLU. It has been selected for its ability to recognize CLU in immunohistochemical staining and western blotting.
Usage
Western blotting: 0.5-2µg/mL;
Immunohistochemistry: 5-20µg/mL;
Immunocytochemistry: 5-20µg/mL;
Optimal working dilutions must be determined by end user.
Storage
Store at 4°C for frequent use. Stored at -20°C in a manual defrost freezer for two year without detectable loss of activity. Avoid repeated freeze-thaw cycles.
Stability
The thermal stability is described by the loss rate. The loss rate was determined by accelerated thermal degradation test, that is, incubate the protein at 37°C for 48h, and no obvious degradation and precipitation were observed. The loss rate is less than 5% within the expiration date under appropriate storage condition.
Giveaways
Increment services
-
 Antibody Labeling Customized Service
Antibody Labeling Customized Service
-
 Protein A/G Purification Column
Protein A/G Purification Column
-
 Staining Solution for Cells and Tissue
Staining Solution for Cells and Tissue
-
 Positive Control for Antibody
Positive Control for Antibody
-
 Tissue/Sections Customized Service
Tissue/Sections Customized Service
-
 Phosphorylated Antibody Customized Service
Phosphorylated Antibody Customized Service
-
 Western Blot (WB) Experiment Service
Western Blot (WB) Experiment Service
-
 Immunohistochemistry (IHC) Experiment Service
Immunohistochemistry (IHC) Experiment Service
-
 Immunocytochemistry (ICC) Experiment Service
Immunocytochemistry (ICC) Experiment Service
-
 Flow Cytometry (FCM) Experiment Service
Flow Cytometry (FCM) Experiment Service
-
 Immunoprecipitation (IP) Experiment Service
Immunoprecipitation (IP) Experiment Service
-
 Immunofluorescence (IF) Experiment Service
Immunofluorescence (IF) Experiment Service
-
 Buffer
Buffer
-
 DAB Chromogen Kit
DAB Chromogen Kit
-
 SABC Kit
SABC Kit
-
 Long-arm Biotin Labeling Kit
Long-arm Biotin Labeling Kit
-
 Real Time PCR Experimental Service
Real Time PCR Experimental Service
Citations
- Deficiency of Clusterin Exacerbates High-Fat Diet-Induced Insulin Resistance in Male Mice Pubmed: 24684302
- Time-Dependent Decrease of Clusterin as a Potential Cerebrospinal Fluid Biomarker for Drug-Resistant Epilepsy.Pubmed: 24488574
- Serum Amyloid A and Clusterin as Potential Predictive Biomarkers for Severe Hand, Foot and Mouth Disease by 2D-DIGE Proteomics AnalysisPubmed:25268271
- Proteomic analysis of human plasma and peripheral blood mononuclear cells in Systemic Lupus Erythematosus patients.pubmed:28390925
- Proteomics Analysis of Blood Serums from Alzheimer's Disease Patients Using iTRAQ LabelingTechnology.pubmed:27911324
- Regulatory effects of simvastatin and apoJ on APP processing and amyloid-β clearance in blood-brain barrier endothelial cellspubmed:28941799
- Clusterin, a New Cerebrospinal Fluid Biomarker in Severe Subarachnoid Hemorrhage: A Pilot Studypubmed:28803177
- Screening for immune-potentiating antigens from hepatocellular carcinoma patients after radiofrequency ablation by serum proteomic analysisPubmed:29386009
- High serum clusterin levels are correlated with premature coronary artery disease in a Chinese populationPubmed: 30659732
- Discovery and validation of FBLN1 and ANT3 as potential biomarkers for early detection of cervical cancer33602229